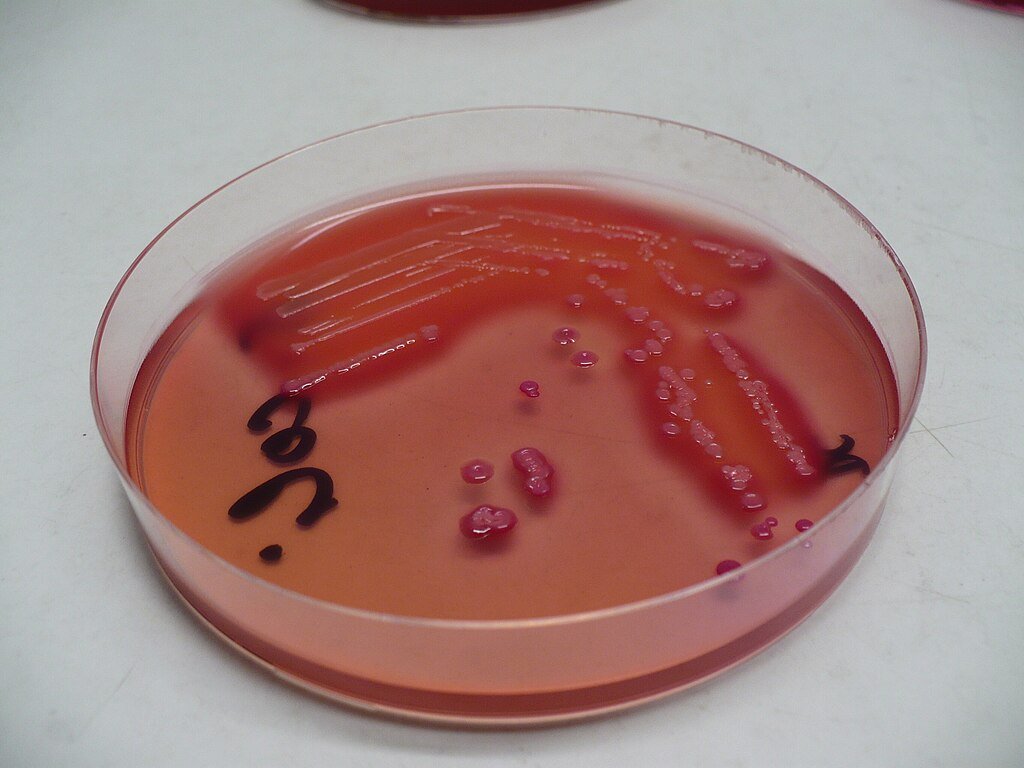

Researchers have uncovered the bacterial causes of exudative cloacitis, a painful disease affecting the critically endangered kākāpō. By sequencing samples from infected birds, scientists at the University of Otago identified three bacterial species strongly linked to the condition. These findings open the door for improved treatment and conservation strategies.
Understanding Exudative Cloacitis

Exudative cloacitis leads to inflammation in the digestive and reproductive tracts, causing discomfort and potential long-term health complications. The disease has persisted in the kākāpō population for over twenty years, but until now, its exact bacterial origin remained unknown.
Identifying the Bacterial Culprits
Researchers found that three bacterial species are associated with the disease: extraintestinal pathogenic Escherichia coli, Enterococcus faecalis, and Streptococcus gallolyticus. These microbes likely originate from environmental sources such as soil, water, or cross-species transmission, highlighting the importance of studying ecological factors affecting the birds’ habitats.
Implications for Conservation
Kākāpō numbers remain critically low, making disease outbreaks a significant threat to their survival. With this new understanding of the bacteria responsible for cloacitis, scientists can work toward targeted treatments, improved habitat management, and biosecurity measures to prevent future infections. Ongoing studies may explore the development of immune-supporting medications or vaccines designed specifically for kākāpō.
Conclusion

This research marks an important step in understanding exudative cloacitis and enhancing kākāpō conservation efforts. By identifying the bacterial culprits, scientists can refine treatment approaches and create preventive strategies that protect one of the world’s rarest parrots, ensuring a healthier population for the future.
Source:
